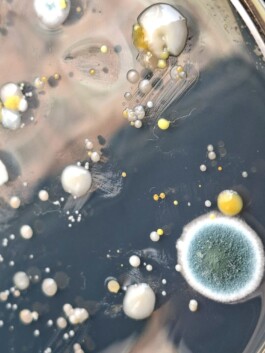
Julie C. Stamm

Julie C. Stamm is a dance and media artist working between choreography, technology, and neuroaesthetics. Her practice explores the interplay between physical and digital bodies through systems of sensing, feedback, and participation. She develops performances and installations that translate movement into data and back into embodied experience. Currently based in Germany, they work across Europe.